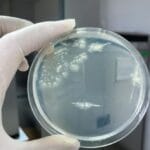
Microbial Art: 10 Cool Facts About Bacteria Paintings

Dictators, despots, and tyrants: history is full of them. While they often wield immense power, their reigns are rarely peaceful. Many meet violent ends, a fate some might call just deserts. Here are ten such despots who met untimely deaths.
Vidkun Quisling (Norway)
Vidkun Quisling, born in 1887, is best known for having his name become synonymous with “traitor.” He served in the Norwegian Army and later founded the fascist Norwegian National Unity Party in 1933. Quisling urged Adolf Hitler to invade Norway, which the Nazis did in 1940.
Appointed “minister president” by the German overlord Josef Terboven, Quisling effectively became Norway’s dictator. He attempted to Nazify Norway, leading to the deaths of nearly 1,000 Norwegian Jews in concentration camps. After the war, Quisling was arrested, tried for treason, and executed by firing squad in October 1945.[1]
Nicolae Ceaușescu (Romania)
Born in 1918, Nicolae Ceaușescu joined the Romanian Communist Party in the 1930s. He rose to power after his mentor, Gheorghe Gheorghiu-Dej, died in 1965. Ceaușescu’s secret police, the Securitate, maintained an iron grip on the Romanian people, crushing any dissent.
The regime eventually fell in December 1989, amidst widespread rebellions in Eastern Europe. Ceaușescu and his wife, Elena, were captured while trying to escape and were executed by firing squad on Christmas Day 1989.[2]
Francisco Macías Nguema (Equatorial Guinea)
Francisco Macías Nguema became the first president of Equatorial Guinea in 1968 but quickly abandoned democracy. A 1973 plebiscite gave him complete control with a reported 99.9% approval. Nguema’s rule became increasingly eccentric and cruel, with his regime murdering approximately 80,000 people out of a population of 400,000.
In 1979, Nguema was overthrown in a coup led by his nephew, Obiang Nguema Mbasogo. He was tried on charges of genocide, embezzlement, and treason, and subsequently executed.[3]
Park Chung-Hee (South Korea)
Park Chung-Hee seized power in South Korea in 1961 through a military coup. He legitimized his position by winning the presidential election two years later. Chung-Hee established the Korean Central Intelligence Agency (KCIA), using it to repress dissent under the guise of anti-communism.
In 1972, he imposed martial law, concentrating power in his hands. An initial assassination attempt in 1974 failed but killed his wife, Yuk Young-Soo. In 1979, Kim Jae-Kyu, the head of the KCIA, assassinated Chung-Hee during a dinner party. Jae-Kyu was later arrested and hanged.[4]
Laurent-Désiré Kabila (Democratic Republic of the Congo)
Laurent-Désiré Kabila took power in the Democratic Republic of the Congo (DRC) in 1997, overthrowing Mobutu Sese Seko. Initially viewed as a liberator, Kabila’s rule soon became authoritarian, with opposition politicians jailed and opposition parties banned.
His reign was marked by chaos, including a rebellion by the Banyamulenge people. In 2001, Kabila was assassinated by one of his bodyguards. His son, Joseph Kabila, succeeded him as president.[5]
Anwar Sadat (Egypt)
Anwar Sadat, who came to power in 1970, maintained an oppressive regime in Egypt, despite being seen as a leader in the West. The Camp David Accords of 1978, the peace treaty between Israel and Egypt, earned him favor internationally, but not universally within Egypt.
In 1981, Sadat jailed 1,500 opponents, leading to his assassination by members of Egyptian Islamic Jihad during a military parade.[6]
Benito Mussolini (Italy)
Benito Mussolini, Italy’s prime minister from 1922, seized absolute power and became known as Il Duce. He allied Italy with Nazi Germany during World War II, resulting in the deaths of nearly half a million Italians.
Overthrown in 1943 but rescued by Nazi troops, Mussolini formed a fascist administration in northern Italy. As the Allies advanced, he attempted to flee to Germany but was captured and executed by Italian partisans. His body and that of his mistress were hung upside down in a Milan plaza.[7]
Ngo Dinh Diem (South Vietnam)
In 1955, Ngo Dinh Diem, with American backing, became prime minister and later president of South Vietnam. He concentrated power among his relatives and suppressed opposition, particularly from the Buddhist population. His regime was marked by the imprisonment and killing of those who opposed him.
In 1963, large demonstrations erupted, and the U.S. withdrew its support. Diem was arrested during a coup and assassinated along with his brother, Ngo Dinh Nhu.[8]
Anastasio Somoza Debayle (Nicaragua)
Anastasio Somoza Debayle was the third member of the Somoza family to serve as president of Nicaragua. Faced with guerilla warfare from the Sandinistas, he ruled under martial law. His immense wealth and the brutality of his National Guard fueled widespread opposition.
In 1979, he lost American support and fled into exile. In 1980, he was assassinated in Paraguay by guerilla gunmen.[9]
Samuel K. Doe (Liberia)
Samuel K. Doe seized power in Liberia in 1980, leading an assault that killed President William R. Tolbert and several of his allies. Doe promoted himself to general and formed a military junta.
His 10-year reign was marked by human rights abuses. In 1990, during a civil war, Doe was captured by forces led by Prince Johnson, and his subsequent torture and killing were filmed and widely circulated.[10]
These leaders, once holding absolute power, ultimately met violent ends, underscoring the volatile nature of despotism. Their stories serve as stark reminders of the consequences of tyranny.
Share your thoughts on these historical figures in the comments below!